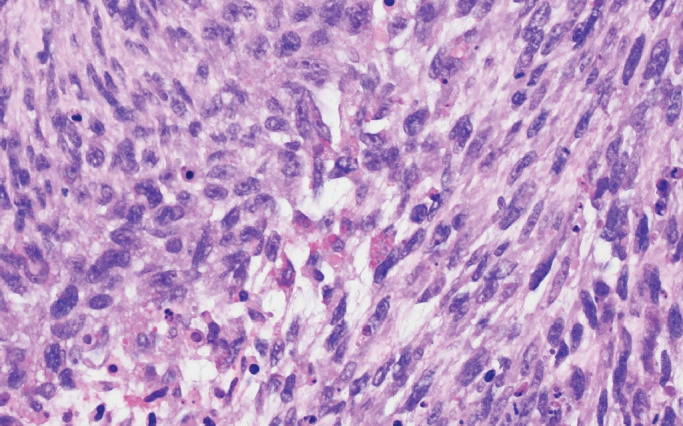

2024 年神经病理学新进展:中枢神经系统世界卫生组织第 5 版更新。
IF 3
Q3 PATHOLOGY
Journal of Pathology and Translational Medicine
Pub Date : 2024-11-01
Epub Date: 2024-09-30
DOI:10.4132/jptm.2024.09.11
引用次数: 0
摘要
世界卫生组织(WHO)《中枢神经系统(CNS)肿瘤分类》第五版于 2021 年发布,距离第四版的更新版仅五年时间。下一代测序、RNA 融合分析和 DNA 甲基化分析等先进的分子检测技术使原有肿瘤类型的分级和分类更加精确,也使新的肿瘤类型得以识别。在此,我们概述了 2021 年世界卫生组织中枢神经系统肿瘤分类的主要更新内容,重点是中枢神经系统肿瘤分子特征的扩展。本文章由计算机程序翻译,如有差异,请以英文原文为准。

What's new in neuropathology 2024: CNS WHO 5th edition updates.
The fifth edition of the World Health Organization (WHO) Classification of Central Nervous System (CNS) Tumors was released in 2021, just five years following the updated fourth edition. Advanced molecular testing such as next-generation sequencing, RNA fusion analysis, and DNA methylation profiling has led to more precise grading and classification of pre-existing tumor types as well as the recognition of new ones. Herein, we outline the major updates of the 2021 WHO Classification of CNS tumors, with emphasis on the expanded molecular characterization of CNS tumors.
求助全文
通过发布文献求助,成功后即可免费获取论文全文。
去求助
来源期刊
CiteScore
5.00
自引率
4.20%
发文量
45
审稿时长
14 weeks
期刊介绍:
The Journal of Pathology and Translational Medicine is an open venue for the rapid publication of major achievements in various fields of pathology, cytopathology, and biomedical and translational research. The Journal aims to share new insights into the molecular and cellular mechanisms of human diseases and to report major advances in both experimental and clinical medicine, with a particular emphasis on translational research. The investigations of human cells and tissues using high-dimensional biology techniques such as genomics and proteomics will be given a high priority. Articles on stem cell biology are also welcome. The categories of manuscript include original articles, review and perspective articles, case studies, brief case reports, and letters to the editor.

 求助内容:
求助内容: 应助结果提醒方式:
应助结果提醒方式:


